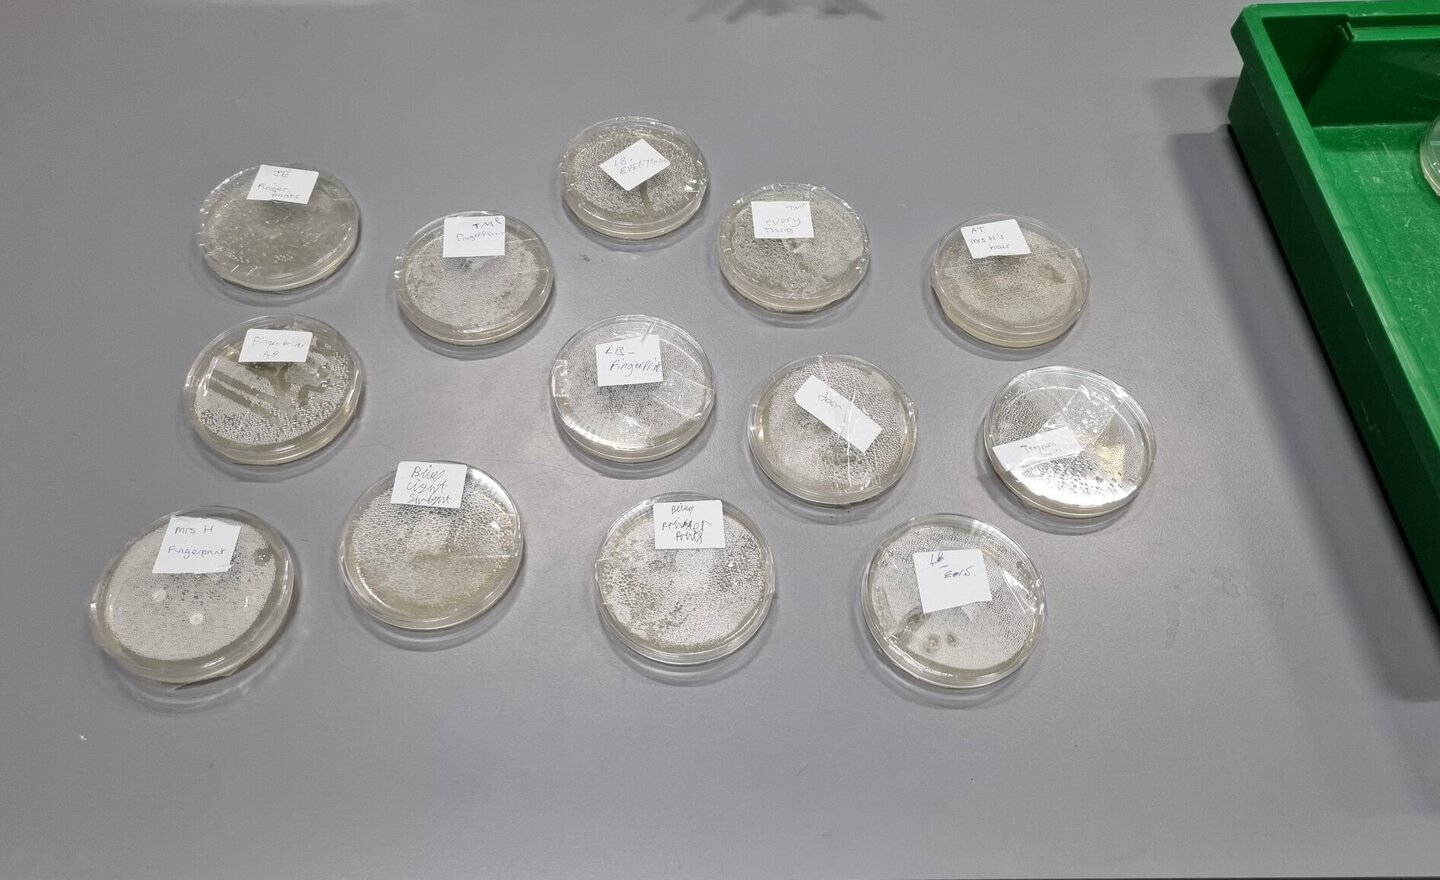
Image of Science Agar Plates

KS2 Chinese New Year Dragon
A KS2 pupil creation in Design Technology where they spent 3 weeks designing and creating a magnificent Dragon.
Chinese New Year or the Spring Festival is a festival that celebrates the beginning of a new year on the traditional lunisolar Chinese calendar. This year it is the year of the Wood…
Making a Modroc Face Mask
A year 7 pupil chose to create a Modroc Mask using the following techniques to gain an AQA Unit Award.
- create a plastic mask mould and cover it with cling film and secure with tape.
- cover the mould by cutting strips of Modroc, dipping into water and smoothing over the mould to apply…
Science Distillation
Year 10 have had another busy lesson separating liquids using simple distillation. They set up their equipment independently, and separated a mixture of ink and water
![]() |
![]() |
Science Filtration and Evaporation
This week Year 10 have been using the separation methods that they have been learning about to separate various mixtures based on their properties. Here they are separating salt from a rock salt mixture that is used to melt ice and snow using filtration and evaporation.
![]() |
… |
Y6 and KS3 Football Tournament
The team had a fabulous day. Pupil attitude and sportsmanship during the games was first class. Training focus moving forward is to improve their match tactics to learn the rules and further understand the different positions that can contribute to their competitive game.
Science Agar Plates
Year 10 have prepared agar plates today with swabs taken from various contact areas around school as part of their Health, Disease and Development of Medicines topic. I wonder what will grow over the weekend?
Art Deco and Ancient Egypt - Competition Winners
Winners announced from the Art Deco Ancient Egypt competition which focused on geometric shapes and symmetry. Pupils were asked to construct a mirror using cardboard and to paint and add art deco detail.
![]() |
![]() |
|
|
![]() |
…
Halloween "Artscape"
Year 9 pupil designed and painted a Halloween art scape using mood boards and experimenting with colour and tone to reflect the meaning of Halloween.. The design was framed and displayed in the pupil entrance to celebrate Halloween.
Virtual Work Experience - VR Headsets
Pupils have had the opportunity to explore work experience virtually using VR headsets. Pupils chose the following sectors to see what these jobs may look like.
- Housing
- The Visitor Sector
- Engineering
Art Deco and Ancient Egypt
Pupils from KS2, 3 and 4 have been learning about Art Deco. A style of art from the 1920s using lots of geometric shapes and symmetry. They were inspired by all the new technology of the time but also Ancient Egypt including the architecture, interior design, jewelry, clothing, clocks and mirrors…
Visual Food Cues and Taste Perception
Year 11 pupils created their own homemade chicken burgers focusing on visual food cues and how it activates the brain regions involved in taste perception - kinesthetic science.
Materials and Their Working Properties
Design Technology pupils looked at different types of materials and their working properties - how the material behaves when it is manipulated, to create their own pumpkin face. Pupils also discussed what happens during the design stage of a project.







…